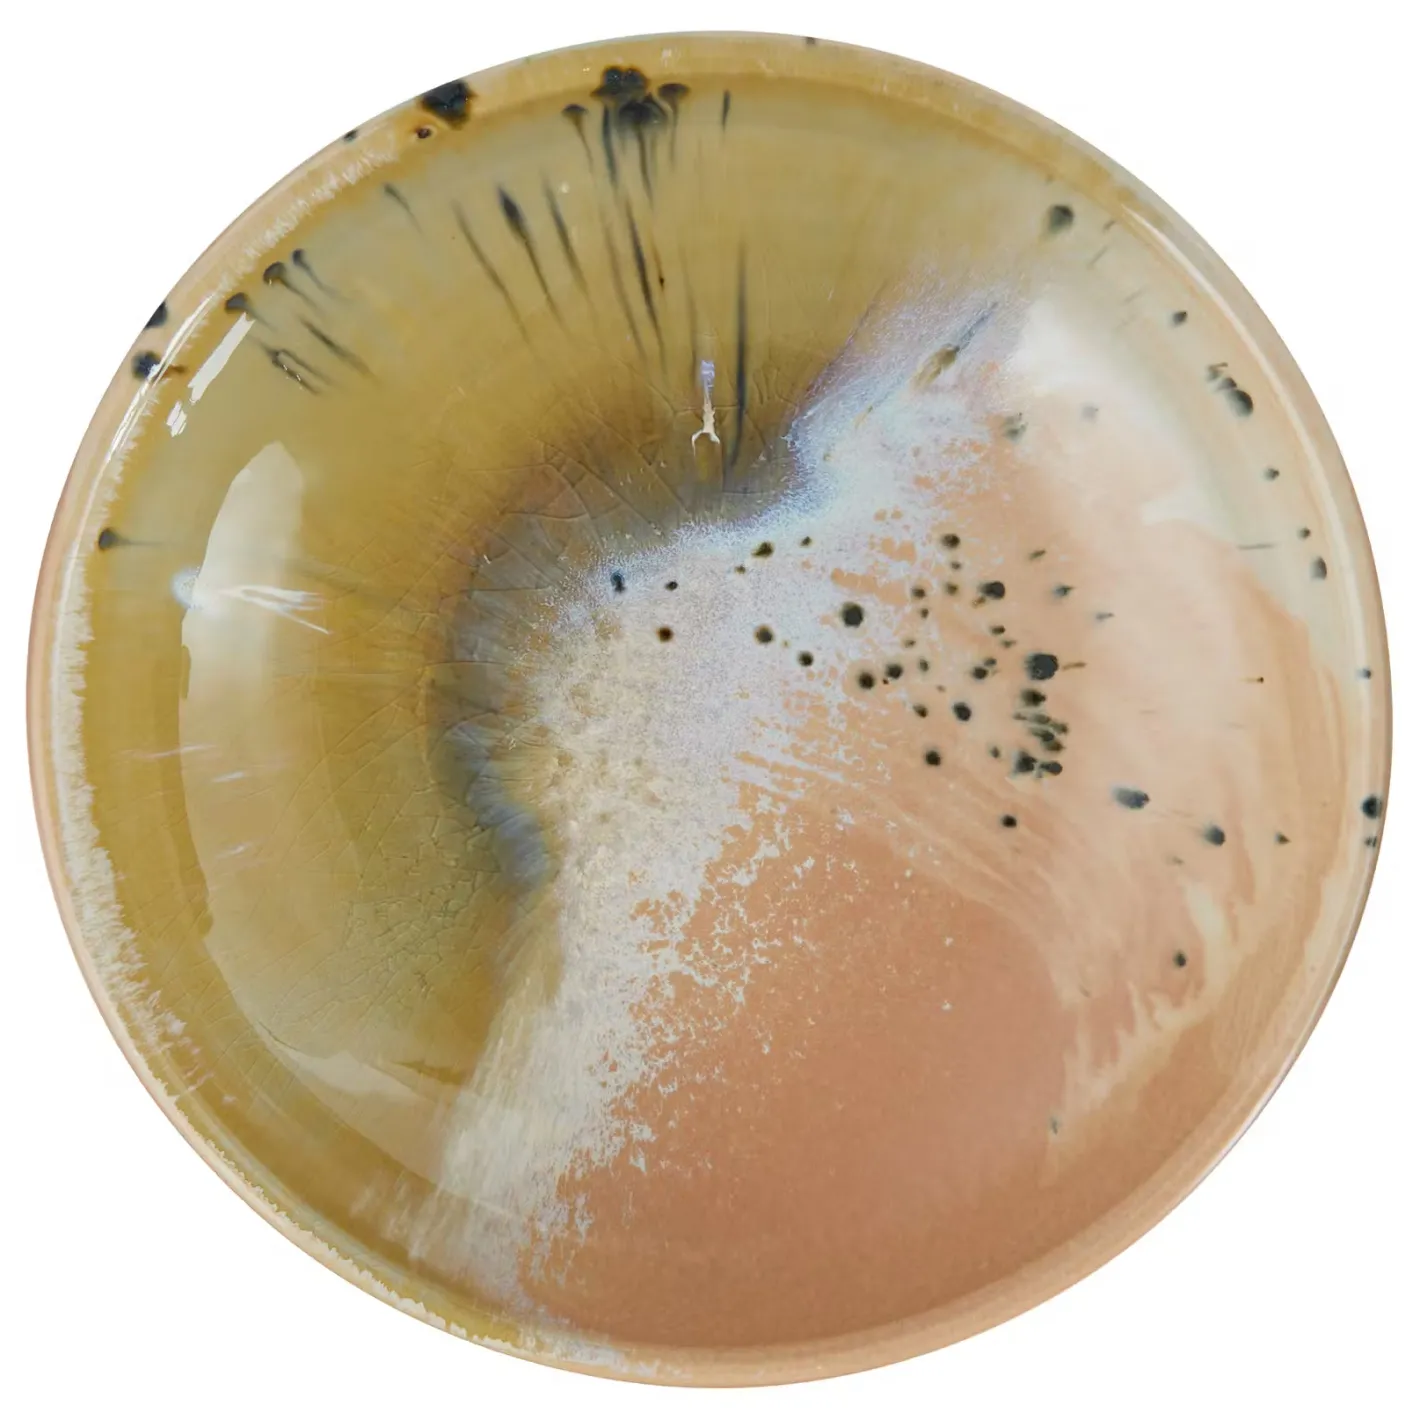
Butlers SINTRA Pastateller Best

Material
- Material: Steinzeug, reaktive Krakelé Glasur
Abmessungen
- Höhe: 6 cm
- Breite: 23 cm
- Tiefe: 23 cm
- Gewicht: 0,76 kg
- Fassungsvermögen: 0,8 l
Pflege
- Pflegehinweise: Spülmaschinengeeignet
Technische Details
Zusätzliche Informationen
- Farbe: Grün
- Anzahl Teile im Set: 1-teilig
- Benutzerhinweise: Lebensmittelkontaktgeeignet, Mikrowellengeeignet
- Geeignet für: Geschirrspüler, Mikrowelle
- Artikelnummer: 000000001000512759
Material
- Material: Steinzeug, reaktive Krakelé Glasur
Abmessungen
- Höhe: 6 cm
- Breite: 23 cm
- Tiefe: 23 cm
- Gewicht: 0,76 kg
- Fassungsvermögen: 0,8 l
Pflege
- Pflegehinweise: Spülmaschinengeeignet
Technische Details
Zusätzliche Informationen
- Farbe: Blau
- Anzahl Teile im Set: 1-teilig
- Benutzerhinweise: Lebensmittelkontaktgeeignet, Mikrowellengeeignet
- Geeignet für: Geschirrspüler, Mikrowelle
- Artikelnummer: 000000001000512762
Beschreibung
Ein einzigartiges Statement-Piece für deinen gedeckten Tisch: Der Sintra Pastateller 22,8 cm Durchmesser zieht mit seinen dynamischen Farbverläufen und abstrakten Mustern alle Blicke auf sich. Hinter dieser beeindruckenden Optik verbergen sich natürlich Glasuren mit individuellem Charakter, veredelt durch eine transparente Krakelé Glasur. Erdverbunden und authentisch entsteht so eine besondere Form von Luxus. Der Steinzeug-Teller ist übrigens spülmaschinengeeignet und mikrowellengeeignet, und für den perfekt gedeckten Tisch gibt es aus der Sintra Geschirrserie weitere Teller, Salatschalen und Servierschalen in verschiedenen Farbvarianten.

Reviews
There are no reviews yet.